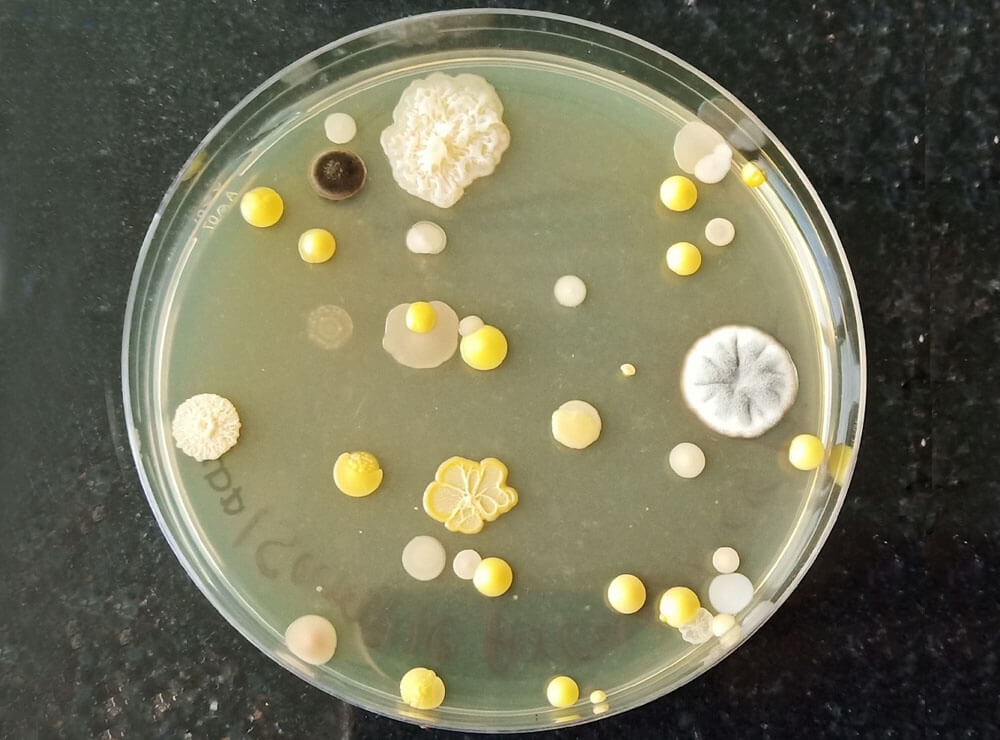

Welcome To MicrobiQ Labs
We are expert in Microbiological Quality Testing Services at our Laboratory and at Customer Site.
Our professional team is highly qualified and seasoned in respective microbiological areas such as Pharmaceutical Microbiology, Cosmetic Microbiology, Aero-Microbiology, Environmental Microbiology, Cell Biology & Molecular Microbiology, Anaerobic Bacteriology, Mycology, Microbial Contamination & Biofilms – Identification & Control, Decontamination & Disinfection, Biocides & Antimicrobials, Microbial Toxins, Clean Room Qualifications, Test Method Development and Validations, Product Quality Review and Improvement Strategies to increase Product Shelf Life. We are expert in Scientific solutions to Microbiological issues.

Registered Organization
Accredited Laboratory







Our Vision
Global Trusted Partner in Microbiological Services

Our Mission

Our Location
MICROBIQ LABS PVT. LTD.
FF-02, 372, Scheme No. 114 Part 1, Vijay Nagar, Indore – 452010 Madhya Pradesh State, India Land mark – Opp Canara Bank

Core Values
We are confident and provide transparent guidance to our valuable customer. We are adhered and strongly determined on our core values to drive services and be trustable global partner.
- Quality
- Integrity
- Commitment
- Quick Response
Microbiological Quality Testing Services
Our growing portfolio caters broad range of Expert Microbiological Testing Services as per standards in following areas.


Antimicrobial Tests
Preservative / Antimicrobial agents / Biocides are antimicrobial in nature inhibits or kills microbial growth and play important role and controls bioburden levels in product life cycle.

Microbiological Monitoring
Air-borne biological agents such as bacteria and mould can cause serious health problems as well as contaminate product and process and damage to high revenues.


Microbiological Tests
Microbial enumerations / counts and microbial identification / detections are important in bioburden / microbial contamination controls.

Expert Microbiological Testing Services by
Dr. Yogesh Vyas
+91-9949411776
microbiqlab@gmail.com
Our Strength

Supports Progressive / Consistent Product Quality Improvement
We follow product specific standards and conduct independent researches to improve product quality and keep informed to customer.

Customer Partnership
Our customer communications persist for long time professional relationship to help in product quality improvement and well as provide transparent guidance.

1st Microbiology Lab dedicated for Comprehensive Test / Study Reports
MicrobiQ is the First dedicated Expert Microbiological Services Laboratory in India offering comprehensive microbiological studies / Tests.

Economic Pricing
We have the distinct advantage of offering expert microbiological quality services at an affordable price.

Timely Deliver Test Results
MicrobiQ Labs Expert Team
Highly Qualified and Professional Skilled Team

Dr. Yogesh Vyas



